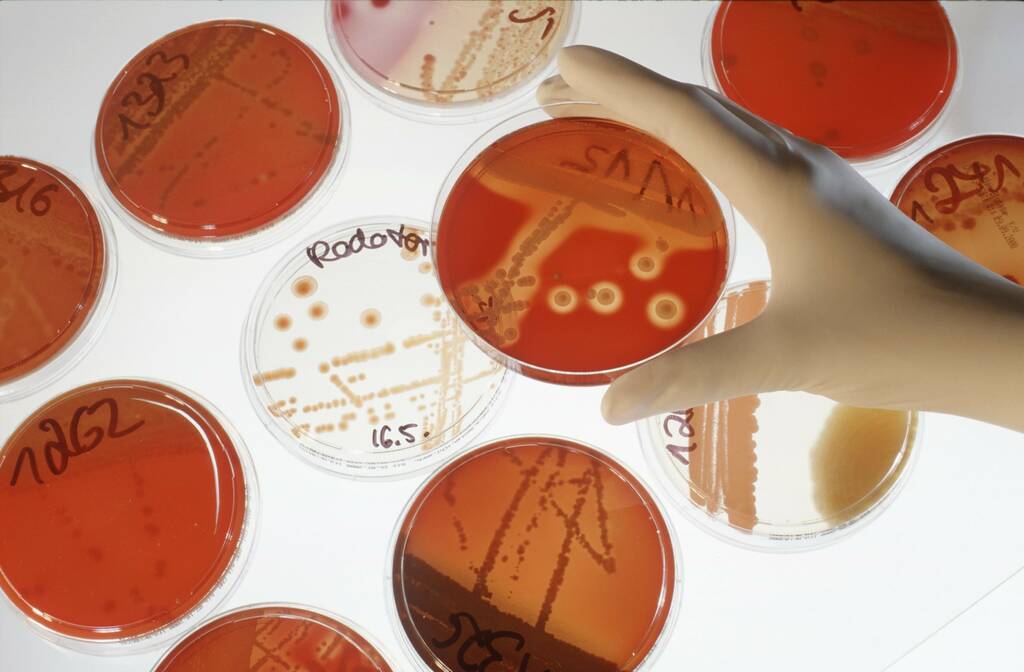
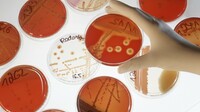

Prologue
Goto first page"One Health" Against the next pandemic
Text: Samuel Schlaefli
Design: Seraina Hügli & Lucas Pfister (Capisci)
Overview
Goto first pageClose to the animal
Close to the animalFrom veterinarian in the Jura to head of research in Abidjan
Virus: HIV
Natural reservoir: Chimpanzees for HIV Type 1, and soot mangabey (baboon species) for HIV type 2
Intermediate host: none
First occurrence: Kinshasa, Democratic Republic of Congo
Distribution: Worldwide
Symptoms: Flu-like symptoms, fever, weight loss, destruction of T cells and the resulting immunodeficiency
Dead: Up to 47.8 million (as of end 2020)
Virus: H5N1
Natural reservoir: Wild waterfowl
Intermediate host: poultry
First occurrence: Guangdong, China
Distribution: Southeast Asian countries (over 100 million ducks and chickens died or had to be slaughtered)
Symptoms: High fever, shortness of breath, pneumonia
Dead: 455 (as of December 2020)
Virus: Ebola virus
Natural reservoir: Probably African fruit bats and bats
Intermediate host: Monkeys
First occurrence: Simultaneously in Democratic Republic of Congo and South Sudan
Distribution: Largest outbreak to date between 2014 and 2016 in Guinea, Liberia and Sierra Leone
Symptoms: Fever, vomiting, diarrhea
Dead: 11,323 (2014 - 2016)
Virus: SARS-CoV
Natural reservoir: bat (horseshoe bats) Intermediate host: Viverrids (masked palm civet)
First occurrence: Guangdong, China
Distribution: 26 countries in Asia, Europe, North America and South America
Symptoms: high fever, pneumonia
Deaths: 916 (as of October 2021)
Virus: MERS-CoV
Natural reservoir: Probably bats
Intermediate host: Camels
First occurrence: Saudi Arabia
Distribution: 27 countries, large outbreak in South Korea in 2015
Symptoms: Fever, diarrhea, shortness of breath
Deaths: 888 (as of October 2021)
Virus: SARS-CoV-2
Natural reservoir: Probably bats
Intermediate host: Unknown (as of February 2022)
First occurrence: Wuhan, China
Distribution: Worldwide
Symptoms: Severe fever, chest pain, pneumonia, loss of smell and/or taste.
Deaths: 5`727`698 (as of 5.02.2022)
1920s HIV (Human Immunodeficiency Virus)
Virus: HIV
Natural reservoir: Chimpanzees for HIV Type 1, and soot mangabey (baboon species) for HIV type 2
Intermediate host: none
First occurrence: Kinshasa, Democratic Republic of Congo
Distribution: Worldwide
Symptoms: Flu-like symptoms, fever, weight loss, destruction of T cells and the resulting immunodeficiency
Dead: Up to 47.8 million (as of end 2020)
1996 Avian flu (Highly pathogenic avian influenza)
Virus: H5N1
Natural reservoir: Wild waterfowl
Intermediate host: poultry
First occurrence: Guangdong, China
Distribution: Southeast Asian countries (over 100 million ducks and chickens died or had to be slaughtered)
Symptoms: High fever, shortness of breath, pneumonia
Dead: 455 (as of December 2020)
1976 Ebola (Ebola virus disease)
Virus: Ebola virus
Natural reservoir: Probably African fruit bats and bats
Intermediate host: Monkeys
First occurrence: Simultaneously in Democratic Republic of Congo and South Sudan
Distribution: Largest outbreak to date between 2014 and 2016 in Guinea, Liberia and Sierra Leone
Symptoms: Fever, vomiting, diarrhea
Dead: 11,323 (2014 - 2016)
2003 SARS (Severe acute respiratory syndrome)
Virus: SARS-CoV
Natural reservoir: bat (horseshoe bats) Intermediate host: Viverrids (masked palm civet)
First occurrence: Guangdong, China
Distribution: 26 countries in Asia, Europe, North America and South America
Symptoms: high fever, pneumonia
Deaths: 916 (as of October 2021)
2012 MERS (Middle East respiratory syndrome)
Virus: MERS-CoV
Natural reservoir: Probably bats
Intermediate host: Camels
First occurrence: Saudi Arabia
Distribution: 27 countries, large outbreak in South Korea in 2015
Symptoms: Fever, diarrhea, shortness of breath
Deaths: 888 (as of October 2021)
2019 COVID-19 (Coronavirus disease 2019)
Virus: SARS-CoV-2
Natural reservoir: Probably bats
Intermediate host: Unknown (as of February 2022)
First occurrence: Wuhan, China
Distribution: Worldwide
Symptoms: Severe fever, chest pain, pneumonia, loss of smell and/or taste.
Deaths: 5`727`698 (as of 5.02.2022)
Chad 1998
Chad 1998Vaccinating the goats along with the children
The Era of Pandemics
The Era of Pandemics And the birth of a "One Health" movement
«A world at risk», WHO 2019 A few months before the outbreak of the Corona pandemic, WHO experts issued an urgent warning about the increasing risk of a pandemic. The world is not prepared for a fast-spreading, respiratory-transmitted infection. Due to continuously increasing mobility, a virus or bacterium could spread globally within a very short period. They calculated that today, a contagious virus similar to the Spanish flu of 1918, with a four times larger world population and much more air travel, would be globally distributed in less than 36 hours. The consequences: 50 to 80 million dead, panic, political destabilization and economic collapse.
Council for Agricultural Science & Technology, 2005 A task force consisting of researchers, senior officials from national veterinary services and WHO described the main drivers for the spread of zoonotic pathogens: high population growth, increasing mobility, rampant environmental destruction, new transmission interfaces through the spread of wild animals and the animal trade, profound changes in agriculture, with increasing monocultures, genetically identical animals and overuse of antibiotics. They called on states to invest more in monitoring zoonoses.
«Ecology of Zoonoses», W. Karesh et al., Lancet 2012 A team of authors led by William Karesh, a US-based “One Health” pioneer, points out that zoonotic infectious diseases cause one billion cases annually and lead to millions of deaths. The authors identify endemic zoonoses as the greatest risk to the health of the global community. They call for increased collaboration between doctors in clinics, public health experts, ecologists, veterinarians and economists to better understand the causes of zoonoses and develop effective prevention measures.
At eye level
At eye levelHealing with the Mayas in Guatemala
One man, one mission
One man, one missionOn Roadshow for a Global "One Health”
Director of the Centre for Viral Zoonoses, University of Pretoria
Co-director of The Lancet “One Health” Commission
State Secretary, German Federal Ministry for Economic Cooperation and Development
Epidemiologist and Vice Director Cirad
Professor of Epidemiology, Swiss TPH
Wanda Markotter
Director of the Centre for Viral Zoonoses, University of Pretoria
John Amuasi
Co-director of The Lancet “One Health” Commission
Maria Flachsbarth
State Secretary, German Federal Ministry for Economic Cooperation and Development
Marisa Peyre
Epidemiologist and Vice Director Cirad
Jakob Zinsstag
Professor of Epidemiology, Swiss TPH
Ethiopian pilot
Ethiopian pilotFor holistic zoonosis surveillance
"One Health" quo vadis?
"One Health" quo vadis?Towards a society of human-animal-environment relations
Imprint
Goto first pageSources and image rights
Goto first page Goto first pageBack to the Start
Goto first pageVideo Guatemala-Projekt
Goto first pageFotoserie Äthiopien
Goto first page Goto first page Goto first page Goto first page Goto first page Goto first page Goto first page Goto first pageRisky proximity
Risky proximity


Most epidemiologists and virologists have now concluded that SARS-CoV-2 has a zoonotic origin. The alternative "lab leak" theory, according to which the virus escaped from a laboratory in Wuhan, could not be completely disproved yet, but is considered unlikely by most experts. But why did the decisive "spillover" of the virus from animals to humans take place here, at a market in the center of Wuhan, a city of 9 million people in Hubei Province, 800 kilometers west of Shanghai?
A good insight into the conditions on the ground is provided by a study published in July 2021 in the scientific journal "Nature" by a group led by Oxford zoologist Chris Newman with the participation of researchers from China and Wuhan. Xiao, one of the researchers working at the Lab Animal Research Center in Wuhan, visited 17 "wet markets" in Wuhan selling wild animals every month between May 2017 and November 2019, including the notorious Wuhan Huanan Seafood Wholesale Market. There he talked to the sellers and noted which animals were sold, how many of them, at what price and whether the animals came from farms or were caught in the wild.
The actual purpose was to collect data on the spread of the SFTS virus, a zoonotic infectious disease that has been endemic in parts of China, Korea, Vietnam and Japan since 2011, killing up to 30 per cent of those infected. Today, his data serve to shed some light on the origins of the Covid-19 pandemic. For example, it seems unlikely that SARS-CoV-2 was transmitted to humans by a pangolin or a bat, as was assumed at the beginning of the pandemic. This is because neither species was sold on the market, according to the study.

Vertiefung: Globale Investitionen gegen die nächste Pandemie
Global investment against the next pandemic
Global investment against the next pandemic


But prevention is not particularly "sexy" politically. It does not win elections. It is only when a virus is raging, taking human lives and the humanitarian consequences become obvious, that political capital can be made from pandemic control. Even if it is then merely a matter of combating the symptoms with medication, vaccinations and protective measures.
A blatant example: Donald Trump deliberately cut back on investments in pandemic prevention during his term in office. In September 2019, three months before the Covid-19 outbreak in Wuhan, the president withdrew funding from the world's most comprehensive pandemic-early-warning system, “Predict”. Dozens of researchers had to be dismissed. Although funding was briefly restored after the emergence of SARS-CoV-2, the damage had already been done.
In the following overview, we describe the largest global anti-zoonosis programs (hover over logos for more information).

This $200-million project was initiated in 2009 by the American development agency USAID together with the University of California. It was implemented with the "Eco Health Alliance" in cooperation with universities, conservation projects and natural history museums in 30 partner countries. So-called "virus hunters" collected over 140,000 biological samples worldwide, including mucus and saliva samples from over 10,000 bats and 2,000 other mammals. A total of 1,200 potentially zoonotic viruses were identified, 160 of which were new coronaviruses. The program officially ended in September 2020.
This $100-million project aims at a better understanding of zoonoses and their risks. The monitoring of viruses, which was started in "Predict", will be continued. In addition, tests for and measures against the spread of zoonoses will be developed. The project is funded by USAID and implemented by Tufts University together with a global consortium of experts from the human, veterinary and environmental sciences.
For years, ideas have been circulating for a kind of "Human Genome Project" for viruses. In 2016, researchers, UN representatives, foundations and interested parties from the private sector met and founded the “Global Virome Project”. The vision: to sequence and characterize 99 per cent of the world's viruses with zoonotic and pandemic potential and to develop an early warning system based on this. The initiators are already talking about the "beginning of the end of the pandemic era". The big sequencing offensive is expected to cost around $4 billion, i.e., around 70 per cent of the WHO's current annual budget.
Predict
This $200-million project was initiated in 2009 by the American development agency USAID together with the University of California. It was implemented with the "Eco Health Alliance" in cooperation with universities, conservation projects and natural history museums in 30 partner countries. So-called "virus hunters" collected over 140,000 biological samples worldwide, including mucus and saliva samples from over 10,000 bats and 2,000 other mammals. A total of 1,200 potentially zoonotic viruses were identified, 160 of which were new coronaviruses. The program officially ended in September 2020.
Stop Spillover
This $100-million project aims at a better understanding of zoonoses and their risks. The monitoring of viruses, which was started in "Predict", will be continued. In addition, tests for and measures against the spread of zoonoses will be developed. The project is funded by USAID and implemented by Tufts University together with a global consortium of experts from the human, veterinary and environmental sciences.
Global Virome Project
For years, ideas have been circulating for a kind of "Human Genome Project" for viruses. In 2016, researchers, UN representatives, foundations and interested parties from the private sector met and founded the “Global Virome Project”. The vision: to sequence and characterize 99 per cent of the world's viruses with zoonotic and pandemic potential and to develop an early warning system based on this. The initiators are already talking about the "beginning of the end of the pandemic era". The big sequencing offensive is expected to cost around $4 billion, i.e., around 70 per cent of the WHO's current annual budget.
Picture series Chad
Goto first page Goto first page Goto first page Goto first page Goto first page Goto first page Goto first page Goto first page Goto first page Goto first page Goto first page1 Zoonoses
Goto first page Goto first page Goto first page Goto first page Goto first pageOne Health One Health in Switzerland
Hesitant steps
Hesitant steps


This is one of the reasons why a team succeeded in producing a synthetic clone of SARS-CoV-2 as early as mid-February 2020. The basis for this was a virus sequence that had been isolated from a patient in Wuhan, China, and sent to Mittelhäusern. Dozens of research groups worldwide then used the clone for their own Covid-19 research.
We wanted to know from Barbara Wieland, the new head of the Institute of Virology and Immunology, how major she considers the danger of zoonoses for Switzerland.

Environment and zoonoses
When the forests burn, the viruses spread
When the forests burn, the viruses spread


One year later, experts compiled the results of 167 studies on the origin of zoonoses and the causes of pandemics for the UN Environment Programme (UNEP). They concluded that the enormous loss of biodiversity and forest areas strongly drives zoonoses and the associated risk of pandemics. "Pandemics, such as the Covid-19 outbreak, are predictable and predicted consequences of how humans produce food, trade, consume animal meat and change their environment", the report states.

Intro
Intro
 "One Health"
"One Health"
 1
1
 2
2
 3
3
 4
4
 Close to the animal
Close to the animal
 1
1
 2
2
 3
3
 4
4
 5
5
 6
6
 7
7
 8
8
 10
10
 11
11
 Chad 1998
Chad 1998
 1
1
 2
2
 3
3
 4
4
 5
5
 6
6
 The Era of Pandemics
The Era of Pandemics
 1
1
 2
2
 3
3
 4
4
 5
5
 6
6
 7
7
 8
8
 9
9
 At eye level
At eye level
 1
1
 2
2
 3
3
 4
4
 5
5
 6
6
 7
7
 8
8
 9
9
 One man, one mission
One man, one mission
 1
1
 2
2
 3
3
 4
4
 4
4
 5
5
 6
6
 7
7
 8
8
 9
9
 10
10
 Ethiopian pilot
Ethiopian pilot
 1
1
 2
2
 3
3
 4
4
 5
5
 6
6
 7
7
 8
8
 "One Health" quo vadis?
"One Health" quo vadis?
 1
1
 2
2
 3
3
 4
4
 5
5
 6
6
 7
7
 8
8
 9
9
 10
10
 11
11
 12
12
 14
14
 Imprint
Imprint
 1
1
 2
2
 3
3
 7
7
 8
8
 10
10
 6
6
 1
1
 Ethiopia
Ethiopia
 2
2
 3
3
 4
4
 5
5
 6
6
 7
7
 8
8
 Risky proximity
Risky proximity
 2 Number
2 Number
 3
3
 4
4
 5 Quote
5 Quote
 6
6
 7
7
 8 Number
8 Number
 9
9
 10 Juhani Grossmann
10 Juhani Grossmann
 11
11
 12 Number
12 Number
 13
13
 Global investment against the next pandemic
Global investment against the next pandemic
 2
2
 3
3
 3
3
 4
4
 5 Quote
5 Quote
 Chad
Chad
 T
T
 T
T
 T
T
 T
T
 T
T
 T
T
 T
T
 T
T
 T
T
 T
T
 Deadly viral spillovers
Deadly viral spillovers
 1
1
 2 Number
2 Number
3
3
 4 Number
4 Number
 Hesitant steps
Hesitant steps
 1
1
 2
2
 When the forests burn, the viruses spread
When the forests burn, the viruses spread
 1 Number
1 Number
 2
2
 3 Video Giger
3 Video Giger
 4 Number
4 Number
 5
5
 6
6
 7
7
 8
8
 9
9